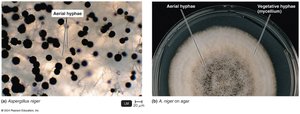
Photomicrograph of Aspergillus niger showing aerial and vegetative hyphae

Back
BackFungi: Structure, Reproduction, and Medical Importance
Study Guide - Smart Notes

Fungi: Structure, Reproduction, and Medical Importance
Introduction to Fungi
Fungi are a diverse group of eukaryotic organisms with over 100,000 known species. They play crucial roles in ecosystems as decomposers, symbionts, and pathogens. Mycology is the scientific study of fungi, which includes molds, yeasts, and mushrooms.
Chemoheterotrophs: Fungi obtain nutrients by absorbing dissolved organic matter.
Saprobes: Most fungi decompose dead organic material, recycling essential elements.
Symbiosis: Mycorrhizae form mutualistic relationships with plant roots, enhancing water and nutrient absorption.
Industrial Importance: Fungi are used in food production (e.g., bread, cheese), fermentation, and antibiotic synthesis.
General Characteristics of Fungi
Cell Walls: Composed mainly of chitin (never peptidoglycan).
Osmotic Pressure: More resistant than bacteria, allowing growth in hypertonic environments.
Optimal pH: Around 5, favoring acidic conditions.
Growth Substrate: Prefer carbohydrates as a nutrient source.
Respiration: Molds are typically aerobic; yeasts are facultative anaerobes.
Extracellular Digestion: Fungi secrete enzymes to break down complex molecules outside their cells, then absorb the simpler nutrients.
Comparison of Fungi and Bacteria
Fungi and bacteria differ in cell structure, metabolism, and ecological roles. (See Table 12-1 in the textbook for a detailed comparison.)
Vegetative Structures of Fungi
Molds and Fleshy Fungi
The main body of a mold is called a thallus, which consists of long filaments known as hyphae. A mass of hyphae forms a mycelium.
Septate Hyphae: Contain cross-walls (septa) dividing the hyphae into distinct, uninucleate cell-like units.
Coenocytic Hyphae: Lack septa and are multinucleate.
Vegetative Hyphae: Involved in nutrient absorption.
Aerial Hyphae: Involved in reproduction, often bearing spores.

Yeasts
Yeasts are unicellular, nonfilamentous fungi. They reproduce by budding or fission.
Budding Yeasts: Divide unevenly, forming a small bud that grows and detaches from the parent cell.
Fission Yeasts: Divide evenly to produce two new cells.
Dimorphic Fungi: Exhibit both yeastlike and moldlike forms, depending on environmental conditions.


Fungal Reproduction and Life Cycle
Asexual Reproduction
Fungi reproduce asexually by forming spores through mitosis. These spores germinate to produce new individuals genetically identical to the parent.
Conidiospore: Not enclosed in a sac.
Arthroconidia: Formed by fragmentation of septate hyphae.
Blastoconidia: Buds from the parent cell.
Chlamydoconidium: Thick-walled spore within a hyphal segment.
Sporangiospore: Enclosed in a sac (sporangium).

Sexual Reproduction
Sexual reproduction in fungi involves the fusion of nuclei from two opposite mating types, resulting in genetic recombination. The process occurs in three phases:
Plasmogamy: Fusion of the cytoplasm from two parent mycelia.
Karyogamy: Fusion of the nuclei to form a diploid zygote.
Meiosis: The diploid nucleus divides to produce haploid sexual spores.
Types of sexual spores include zygospores, ascospores, and basidiospores.
Classification of Fungi
Mucoromycota (Conjugation Fungi)
Hyphae: Coenocytic (non-septate).
Asexual Spores: Sporangiospores.
Sexual Spores: Zygospores, formed by fusion of similar cells.
Example: Rhizopus stolonifer (black bread mold).

Microsporidia
Reproduction: No observed sexual reproduction, but likely occurs in a host.
Cell Structure: Lack mitochondria.
Ecology: Obligate intracellular parasites.
Diseases: Chronic diarrhea, keratoconjunctivitis.
Ascomycota (Sac Fungi)
Hyphae: Septate.
Asexual Spores: Conidiospores.
Sexual Spores: Ascospores, formed in a saclike ascus.
Anamorphic Fungi: Lost ability to sexually reproduce.

Basidiomycota (Club Fungi)
Hyphae: Septate.
Asexual Spores: Conidiospores.
Sexual Spores: Basidiospores, formed externally on a basidium.

Fungal Diseases (Mycoses)
Types of Mycoses
Systemic Mycoses: Deep infections affecting multiple tissues/organs, often acquired by inhalation of spores (e.g., Coccidioides immitis, Histoplasma capsulatum).
Subcutaneous Mycoses: Infections beneath the skin, often from puncture wounds (e.g., Sporothrix schenckii).
Cutaneous Mycoses: Affect hair, skin, and nails; produce keratinase (e.g., Tinea or ringworm).
Superficial Mycoses: Localized on hair shafts or surface skin cells (e.g., Piedras).
Opportunistic Mycoses: Caused by normally harmless fungi in immunocompromised hosts (e.g., Candidiasis).
Examples of Systemic Mycoses
Coccidioidomycosis: Caused by Coccidioides immitis; "Valley fever" in SW USA.
Histoplasmosis: Caused by Histoplasma capsulatum; associated with bird and bat droppings.
Cryptococcosis: Caused by Cryptococcus neoformans; found in soil and pigeon droppings.
Cutaneous Mycoses (Dermatomycoses)
Tinea capitis: Scalp infection.
Tinea corporis: Ringworm of the body.
Tinea cruris: Jock itch.
Tinea pedis: Athlete’s foot.
Tinea unguium: Nail fungus.
Economic Effects of Fungi
Beneficial: Decomposition, food production, fermentation, antibiotics, and symbiotic relationships.
Detrimental: Pathogenicity (disease in plants, animals, humans), and food spoilage.
Summary Table: Selected Features of Fungi and Bacteria
Feature | Fungi | Bacteria |
|---|---|---|
Cell Type | Eukaryotic | Prokaryotic |
Cell Wall | Chitin | Peptidoglycan |
Nutrition | Chemoheterotroph | Varied (chemo- and photo-) |
Reproduction | Sexual & Asexual (spores) | Binary fission, spores (rarely sexual) |
Habitat | Moist, slightly acidic | Varied |
Pathogenicity | Some species | Many species |
Additional info: Table entries inferred from standard microbiology comparisons.
